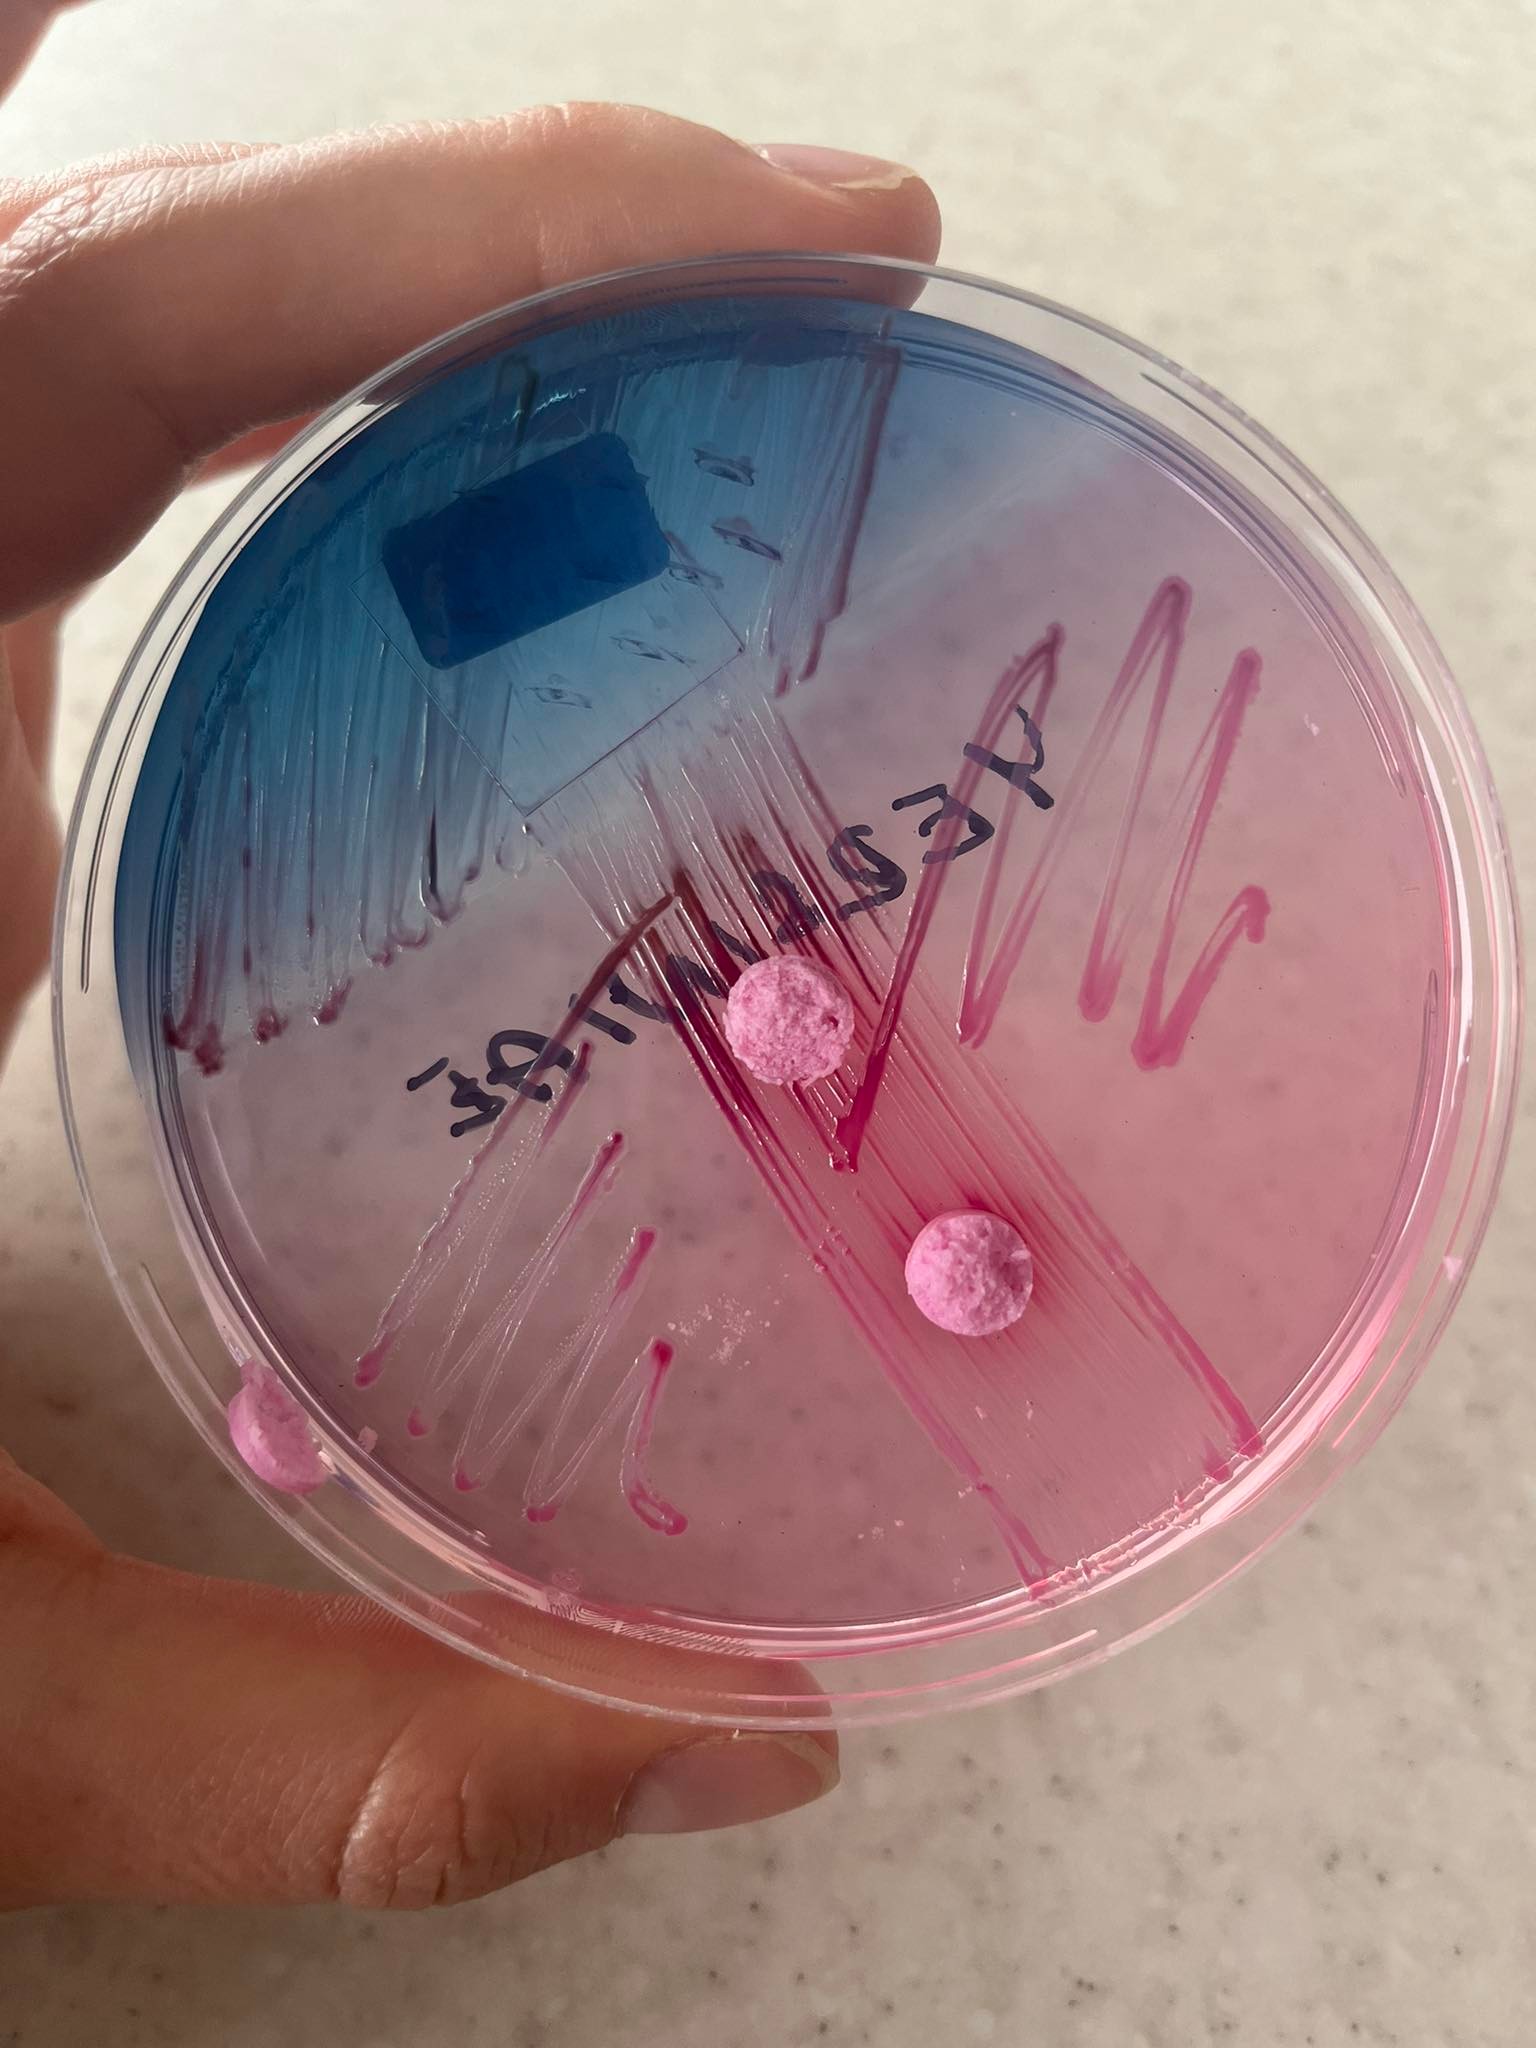

(100% důležité, 0% prokrastinace)
(fakt přísahám)

(trust me, I am a cat)
(you like mustard colour, right? or am i just stupid?)
Mám nostalgii na to, jak jsem já prožíval mononukleózu, takže jsem sestavil tento balíček, abys i ty mohla mít stejný požitek z této nemoci!
Ale vůbec nenabádám k prokrastinaci, to vůbec ne!


Click to download

|
Největší Showman (2017) [2.48 GB] - česky + anglicky |  |

|
Brooklyn Nine-Nine [1.17 GB] - anglicky |  |

|
Legenda Korry [1.05 GB] - česky + anglicky |  |
Zatímco jsem ležel pod dekou (od tebe), pročítal jsem knihu "Curse of Strahd", která je klasickým DnD dobrodružstvím s horrorovou upíří zápletkou a nechával se unést myšlenkou, jaké by to bylo si to zahrát s kamarády (rovněž jsem se nechával nést myšlenkou, že mám kamarády)

Click to download

|
Curse of Strahd [40 MB] |  |
Níže je můj "mononukleóza playlist" obsahující vypalovačky všech žánrů, které jsem poslouchal, zatímco jsem se plahočil po ozdravných procházkách za doby těžkého lockdownu.


Balíček s hudbou obsahuje:

Hm... Já to teda musel dělat do školy
Musíš taky točit filmy do školy?
ty vlastně chodíš na vejšku, že ano...?
Takže asi musíš... 🤔
Tady máš potom inspiraci, abys natočila svůj vlastní Majnkraft film
Doufám, že ti tento balíček pomohl najít náplň v době mononukleózy, stejně jako pomohl mně!

Hodně odpočívej!



Kdyby dva lidi měli mononukleózu najednou, jmenovala by se "stereonukleóza"? 🤔
A něco pozitivního? Mohlo to být tohle: